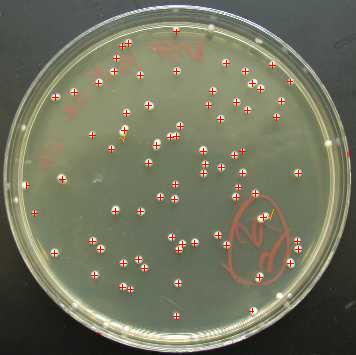

热门供应商更多
PK的排行更多
- 台湾路昌 振动...
- 日本理音 测振仪...
- 日本理音 激...
- 美国康塔仪器 ...
- 北京拓必拓 微...
- 上海舜宇恒平 在...
- 荷兰Skalar...
- 德国德尔格 ...
- 北京拓必拓 超...
- 日本Kanoma...
最新更新的同类仪器更多
最新产品 > 生物分析仪器 > 细胞分析仪 > 细胞分析仪 >郑州中谷 KTY-280-单株种子脱粒机

更新时间:2026-05-23 07:43:36 点击:2381次
| 产品型号 | KTY-280 |
|---|---|
| 参考报价 | 返回顶部 面议 |
| 基本规格 | |
| 产品类型 | 返回顶部 细胞分析仪 |
| 品牌 | 返回顶部 郑州中谷 |
| 产地 | 返回顶部 中国大陆 |
| 返回顶部 我来纠错(有奖) | |
| 技术参数 | |
| 总损失 | 返回顶部 <1.0% |
| 破碎率 | 返回顶部 <1.0% |
| 脱净率 | 返回顶部 ≤1.5%(不含自然破碎) |
| 生产率 | 返回顶部 ≥99% |
| 技术性能指标 | 返回顶部 400-600穗/时(作物含水率14-18%时) |
| 清机时间 | 返回顶部 3秒(该机无死角、抗混杂) |
| 其他信息 | |
| 产品简介 |
在单穗脱粒中,在保纯、保全的同时确保小区种子破损率低; 无死角、不残留、各部可方便打开清机容易,有效防止小区种子之间的混杂; 适应性强,效率高,通过调节下料筒与滚筒的间隙可适用大小不同的玉米穗,且不伤坯芽,并达到理想的脱粒效果。 全封闭机壳、损失小;轮式设计、移动方便;节能环保、经济实用。
|
| 应用文章 | 返回顶部 |
| 产品样本 |
|
| 应用范围 | 返回顶部 |
| 用户数 | 返回顶部 此仪器尚未有用户数 |
| 技术创新 |
|
| 最新动态 | 返回顶部 |
| 相关视频 | 返回顶部 单株种子脱粒机 http://www.126jixie.com/22-2-1.html 小区种子脱粒机 http://www.126jixie.com/22-4-1.html 单株脱粒机 http://www.126jixie.com/22-6-1.html |
| 相关耗材和配件 |
|
| 相关仪器 | 返回顶部 |
| 网友评分 |
5星:0人 4星:0人 3星:0人 2星:0人 1星:0人 返回顶部 |
| 推荐供应商(更多) |
|
暂无评论
- 网友评论:
- 已有0条评论


 搜索
搜索